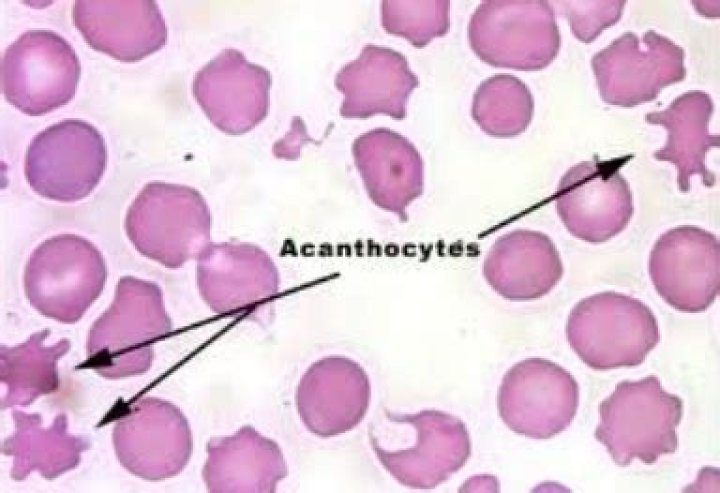

What do acanthocytes indicate?
Acanthocytes have an abnormal amount of these fats, or lipids, in odd proportions. That means the inner and outer surface areas of the blood cells are imbalanced. This causes them to harden, pucker, and form spikes. Severe liver disease is a common cause of acanthocytosis.
Why are acanthocytes seen in liver disease?
In liver dysfunction, apolipoprotein A-II deficient lipoprotein accumulates in plasma causing increased cholesterol in RBCs. This causes abnormalities of membrane of RBC causing remodeling in spleen and formation of acanthocytes.
What do spur cells indicate?
Spur cells, or acanthocytes (from the Greek word acantha, "thorn"), are erythrocytes covered with spikelike projections that vary in width, length, and distribution (see image below). They are characterized by diminished deformability, which is responsible for their entrapment and destruction in the spleen.
What causes acanthocytes and Keratocytes?
Iron deficiency anemia: Acanthocytes are commonly observed in the blood of dogs with iron deficiency anemia. Iron-deficient red blood cells are thought to be mechanically fragile, which results in acanthocyte, schistocyte, and keratocyte formation.
What is the significance of Schistocytes?
The presence of schistocytes (fragmented red blood cells) on the peripheral blood smear suggests red blood cell injury from damaged endothelium and is a characteristic feature of microangiopathic hemolytic anemia.
Acanthocytes (Spur Cells)
16 related questions foundWhat are schistocytes associated with?
Schistocytes are often seen in patients with hemolytic anemia. They are frequently a consequence of mechanical artificial heart valves and hemolytic uremic syndrome, thrombotic thrombocytopenic purpura, among other causes.
Are schistocytes bad?
Introduction to increased destruction of erythrocytes
As noted earlier, the appearance of spherocytes or schistocytes on a peripheral blood film can point to a hemolytic cause for anemia.
What are acanthocytes in dogs?
An acanthocyte is an abnormally shaped erythrocyte. In veterinary medicine, acanthocytes have historically been associated with canine hemangiosarcoma. In human medicine, acanthocytes are rarely observed with neoplastic disease and are more commonly associated with a variety of hereditary and acquired diseases.
Are acanthocytes normal?
Acanthocytes are abnormal red blood cells that have irregular spikes on the cell surface. They're associated with rare inherited conditions as well as more common acquired conditions.
Can Poikilocytosis be normal?
Diagnosis for Poikilocytosis
The total cell count is registered as well as estimating the average volume and variation in size. A blood sample is taken and sent to a lab for analysis. A result is normal when the cells have a normal appearance, and the count is within the normal range.
What happens in individuals with spur cell anemia?
Spur cell anemia is an acquired hemolytic anemia associated with liver cirrhosis and is characterized by the presence of increased large red blood cells, which are covered with spike-like projections that vary in width, length, and distribution.
What is the difference between Acanthocytes and Echinocytes?
Acanthocytes are irregularly spiculated cells (spicules are irregular in size, shape and distribution around the RBC membrane), whereas echinocytes are regularly spiculated cells.
What causes RBCs to be Microcytic?
Microcytic anemias are caused by conditions that prevent your body from producing enough hemoglobin. Hemoglobin is a component of your blood. It helps transport oxygen to your tissues and gives your red blood cells their red color. Iron deficiency causes most microcytic anemias.
When do you see Acanthocytes?
Acanthocytes are found in 50-90% of cells on peripheral blood smear findings in abetalipoproteinemia, which is a rare autosomal recessive disorder with only about 100 cases described worldwide. Acanthocytes are also relatively common in severe liver dysfunction and malnutrition.
What does Anisocytosis mean in a blood test?
Anisocytosis is a condition when the red blood cells are unequal in size. “Aniso” means unequal, and “cytosis” refers to the movement, features, or number of cells. Anisocytosis itself is a nonspecific term, as there are several different ways in which cells can be unequal.
What is zieve syndrome?
Zieve's syndrome (ZS) is a triad of jaundice, hemolytic anemia, and hyperlipidemia that develops secondary to alcohol-induced liver injury [1]. It was first described by Dr. Leslie Zieve in 1957. Patients with ZS present with abdominal pain, nausea, and other nonspecific symptoms [1].
What are the symptoms of Abetalipoproteinemia?
Such symptoms include pale, bulky foul-smelling stools (steatorrhea), diarrhea, vomiting, and swelling (distension) of the abdomen. Affected infants often fail to gain weight and grow at the expected rate (failure to thrive). These symptoms result from poor absorption of fat from the diet.
Is hereditary spherocytosis Coombs positive?
Causes. Spherocytes are found in immunologically-mediated hemolytic anemias and in hereditary spherocytosis, but the former would have a positive direct Coombs test and the latter would not.
What are the symptoms of Sideroblastic anemia?
The signs and symptoms of sideroblastic anemia may include: fatigue, weakness, the sensation of a pounding or racing heart (palpitations), shortness of breath, headaches, irritability, and chest pain.
What are two conditions that cause polycythemia?
What are the risk factors for polycythemia?- Hypoxia from long standing (chronic) lung disease and smoking are common causes of polycythemia. ...
- Chronic carbon monoxide (CO) exposure can also be a risk factor for polycythemia.
What is the difference between Ovalocytes and Elliptocytes?
Elliptocytes: Red blood cells are cigar or pencil shaped with parallel sides and an area of pallor. Ovalocytes: Are red blood cells that are oval or egg shaped.
What does moderate Poikilocytosis mean?
Poikilocytosis means that there are red blood cells of varying shapes on your blood smear. Results from a blood smear can also find mild anisopoikilocytosis. This means that the amount of red blood cells showing varying sizes and shapes is more moderate.
Are schistocytes seen in iron deficiency anemia?
Schistocytes were observed in patients with TMA (n=76), infection (n=20), hematologic malignancy (n=10), mechanical heart valves (n=2), renal failure (n=10), hemoglobinopathy (n=15), iron deficiency anemia (n=1), and megaloblastic anemia (n=1) and in neonates (n=11) (Table 1).
How does HUS cause renal failure?
How does HUS affect the kidneys? In HUS the tiny filter units in the kidneys known as glomeruli become clogged with platelets and damaged red blood cells. This leads to problems with the kidney's ability to filter and eliminate waste products.
What is schistocytes blood test?
Schistocytes or schizocytes are defined as circulating red blood cell fragments. Detection of schistocytes is an important clue for the diagnosis of thrombotic microangiopathy (TMA), which includes both thrombotic thrombocytopenic purpura (TTP) and hemolytic-uremic syndrome (HUS).



